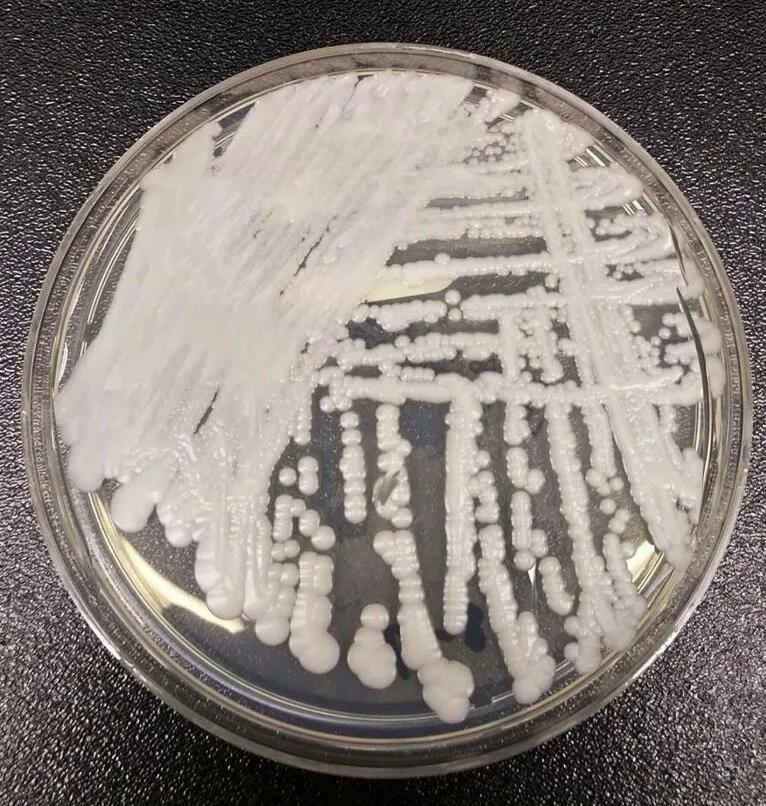
耳念珠菌与普通白色念珠菌有哪些不同？

耳念珠菌与普通白色念珠菌有哪些不同?
耳念珠菌和普通白色念珠菌是两种不同的真菌。以下是它们之间的一些主要区别:
1.菌株概述:
耳道假丝酵母菌(俗称耳念珠菌),属于念珠菌属,是为数不多能够让人类感染侵袭性念珠菌病的真菌,在免疫抑制状态下可以侵入血液,感染心脏、脑等人体重要器官,引起血液感染、泌尿道感染、呼吸道感染等。主要分布于医疗机构和长期护理设施等医疗环境中,易于传播。耳念珠菌在40℃下生长良好,但在42℃时表现出缓慢和微弱的生长。在弱酸或中性条件下最适宜生长,具有高耐盐性。耳念珠菌可以在人体的多个部位生存和定植,包括皮肤、口腔、鼻腔、肠道等。其中,肠道定植是比较常见的现象。而普通白色念珠菌分布较广,是人体自然微生物群落的一部分,常见于口腔、消化道和生殖道等部位。耳念珠菌的检测需要特殊的实验室设备和技术,包括PCR技术、MALDI-TOF质谱技术、基因测序等。而普通白色念珠菌的检测则相对简单,可以采用组织培养、真菌直接涂片、抗原检测等多种方法进行。常引起口腔、阴道等部位的感染。

2.传播途径:
耳念珠菌可以通过直接接触、污染的物品以及医疗设备等途径传播,而普通白色念珠菌主要通过黏膜接触传播,如口腔、阴道等部位。
3.临床表现:
耳念珠菌感染的临床表现包括发热、寒战、虚弱、恶心、呕吐、腹泻、皮疹等。而普通白色念珠菌感染的临床表现则与感染部位有关,如口腔念珠菌病可表现为白色斑点或膜样物质、疼痛等,阴道念珠菌病可表现为瘙痒、白色分泌物、疼痛等。
4.风险群体:
耳念珠菌主要感染免疫系统较弱或免疫抑制的患者,如体弱的老年人、新生儿、糖尿病患者、重症监护室患者及术后患者等,耳念珠菌感染的患者大多同时存在其他基础疾病,包括糖尿病、脓毒血症或血液感染、恶性肿瘤、心血管疾病等。对正常免疫力的健康人群发生感染的风险较低。而普通白色念珠菌感染则更多地发生在免疫系统受损、正在接受化疗或使用广谱抗生素的人群中。
5.治疗方法:
耳念珠菌感染的治疗相对困难,因为该菌株多重耐药性较强,常规抗真菌药物难以有效抑制,尤其是对传统抗真菌药物(如氟康唑、伊曲康唑和两性霉素B)的抗药性很强。目前推荐的治疗方案包括口服或静脉注射多种抗真菌药物的组合使用,以及局部使用酸性溶液进行清洗和消毒。耳念珠菌大多数菌株对氟康唑耐药,不同菌株的抗真菌耐药性存在差异。病死率相对较高。在美国,约90%的菌株对氟康唑具有抗性,30%对两性霉素B具有抗性,5%对抗棘白菌素具有抗性。对于多重耐药性的病例,可使用高剂量多种抗真菌药联合治疗。而普通白色念珠菌感染的治疗则相对简单,常规的抗真菌药物如伊曲康唑、氟康唑等可以有效地治疗该病。病死率相对较低,一般不会引起严重的生命危险。
6.预防措施:
由于耳念珠菌传播范围广、传播速度快,加之多重耐药性的存在,因此防范和控制该病非常重要。建议加强公众宣传和健康教育,提高人们的卫生意识和防范意识,尤其是老年人、免疫系统受损者和患有慢性疾病的人群更应该注意个人卫生和疾病预防。此外,医疗机构也应加强感染控制措施,如严格执行手卫生、器械消毒和隔离预防措施,防止耳念珠菌的交叉感染和传播。
总之,耳念珠菌与普通白色念珠菌在多个方面存在差异,这些差异对于疾病的防治、预防和控制都有着重要的意义。因此,相关的研究和认识需要不断深入和完善,以便更好地应对和控制这两种疾病。